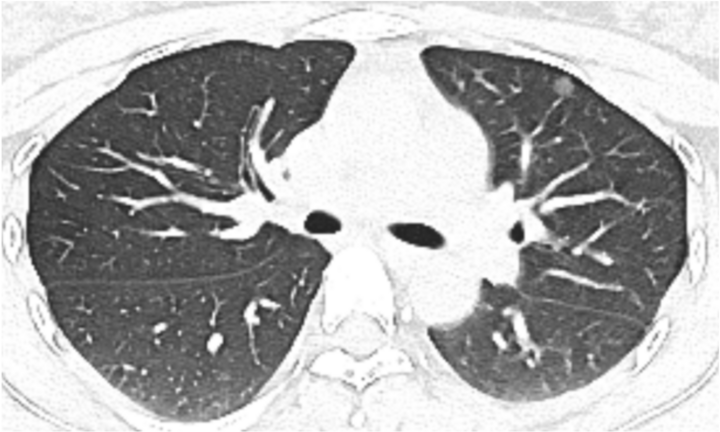

Ung thư phổi, căn bệnh thường được liên tưởng đến người lớn tuổi, giờ đây đang có xu hướng trẻ hóa. Câu chuyện của chị Hoàng, 28 tuổi (Trung Quốc) là minh chứng rõ ràng cho thực tế này. Nhờ phát hiện sớm và công nghệ y học hiện đại, cô vượt qua căn bệnh hiểm nghèo, đồng thời gửi đi thông điệp cảnh báo đến cộng đồng về tầm quan trọng của việc kiểm tra sức khỏe định kỳ.
Hình ảnh kiểm tra phổi của bệnh nhân.
Chị Hoàng, một phụ nữ trẻ đang lên kế hoạch mang thai, gần đây cảm thấy khó chịu ở ngực. Trong một lần khám sức khỏe, chị quyết định chụp CT ngực để kiểm tra. Kết quả, chị có một nốt mờ khoảng 1 cm ở phổi trên bên trái.
Ban đầu, chị không quá lo lắng, nghĩ rằng các nốt ở phổi không phải là hiếm và bản thân còn trẻ, có thể trì hoãn điều trị đến sau khi sinh con. Tuy nhiên, dưới sự thúc giục của gia đình, chị tìm đến bác sĩ Lưu Thịnh Hoa, Phó Giám đốc Khoa Phẫu thuật lồng ngực, Bệnh viện trực thuộc Đại học Y Quảng Châu (Trung Quốc), để được tư vấn.
Sau khi xem xét kỹ lưỡng phim chụp CT, bác sĩ Lưu nhận định, nốt kính mờ này nguy cơ cao là ác tính. Ông chỉ ra rằng, dù hơn 90% các nốt phổi là lành tính, nhưng hình ảnh CT của chị Hoàng cho thấy các dấu hiệu đáng ngờ như gai ngắn và vi mạch trong khối u.
“Khả năng đây là ung thư ác tính rất cao, và việc phẫu thuật sớm là cần thiết trước khi cô mang thai", bác sĩ Lưu khuyên. Lời cảnh báo này khiến chị Hoàng và gia đình sợ hãi, liền thay đổi suy nghĩ và quyết định nhập viện.

Phát hiện sớm là chìa khóa quan trọng trong điều trị ung thư.
Công nghệ hiện đại điều trị ung thư phổi
Để đảm bảo loại bỏ hoàn toàn vùng tổn thương, đội ngũ y bác sĩ sử dụng công nghệ nội soi lồng ngực một cổng kết hợp với hình ảnh ba chiều từ dữ liệu CT. Trước phẫu thuật, các bác sĩ định vị chính xác vị trí khối u thông qua mô phỏng 3D trên máy tính, giúp giảm thiểu sai sót. Ca phẫu thuật chỉ để lại một vết rạch nhỏ khoảng 2-3 cm, ít xâm lấn. Chị Hoàng hồi phục nhanh chóng.
Bác sĩ Lưu giải thích: “Công nghệ hình ảnh 3D cho phép chúng tôi chuyển đổi dữ liệu CT từ 2D sang 3D, kết hợp với các phương pháp định vị hay nhuộm huỳnh quang. Điều này giúp xác định chính xác vị trí, mô phỏng phẫu thuật trước, và bảo tồn tối đa mô phổi lành".
Kết quả giải phẫu bệnh sau phẫu thuật xác nhận nốt kính mờ là ung thư biểu mô tuyến vi xâm lấn - một dạng ung thư phổi giai đoạn đầu. May mắn thay, nhờ can thiệp kịp thời, chị Hoàng tránh được nguy cơ bệnh tiến triển.

Ung thư phổi trẻ hóa
Theo số liệu từ Trung tâm Ung thư Quốc gia Trung Quốc công bố vào tháng 2/2022, ung thư phổi hiện là loại ung thư có tỷ lệ mắc và tử vong cao nhất tại nước này, với 828.000 ca mắc mới và 657.000 ca tử vong mỗi năm.
Đáng chú ý, độ tuổi mắc bệnh ngày càng trẻ hóa, liên quan đến các yếu tố như ô nhiễm không khí, hút thuốc, áp lực cuộc sống và thói quen sinh hoạt không lành mạnh. Sự tiến bộ trong công nghệ chẩn đoán cũng góp phần phát hiện sớm nhiều ca bệnh hơn, đặc biệt ở người trẻ.
Bác sĩ Lưu nhấn mạnh: “Hiệu quả điều trị ung thư phổi giai đoạn đầu và giai đoạn muộn khác nhau rất lớn. Với ung thư giai đoạn đầu, khả năng tái phát sau phẫu thuật rất thấp, trong khi tỷ lệ sống sót 5 năm ở giai đoạn giữa và cuối chỉ khoảng 20%". Trường hợp của chị Hoàng là minh chứng rằng dù không may mắc bệnh nhưng chị may mắn phát hiện sớm và điều trị kịp thời, giúp bảo toàn sức khỏe và tương lai.

Tầm quan trọng của phát hiện sớm
Câu chuyện của chị Hoàng là lời nhắc nhở ung thư phổi không còn là căn bệnh của riêng người lớn tuổi. Các chuyên gia khuyến cáo mọi người, đặc biệt là những ai có triệu chứng như đau ngực, ho kéo dài, nên đi khám chuyên sâu ngay lập tức.
Việc khám sức khỏe định kỳ, kết hợp với các công nghệ chẩn đoán và điều trị tiên tiến như nội soi lồng ngực ít xâm lấn, đang mở ra hy vọng cho nhiều bệnh nhân. Với vết mổ nhỏ, thời gian hồi phục nhanh và hiệu quả cao, những tiến bộ này không chỉ cứu sống mà còn nâng cao chất lượng cuộc sống cho người bệnh.
Chị Hoàng giờ đây đã trở lại cuộc sống bình thường, mang theo bài học quý giá về sức khỏe. Thông điệp từ các bác sĩ rất rõ ràng: đừng chủ quan với những dấu hiệu bất thường, bởi phát hiện sớm có thể là chìa khóa để chiến thắng ung thư.
